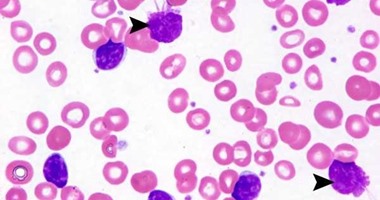

FDA Approves New Drug for Chronic Lymphocytic Cancer
Venetoclax [], which contains the openotoxumab, has been approved for the treatment of adult patients with chronic lymphoblastic leukemia or small lymphoma, the US Food and Drug Administration [FDA] announced yesterday.
Venetoclax will be available in the form of tablets 10, 50 and 100 mg, starting with a five-week intensification dose. The FDA advises doctors to consult with the manufacturer that specifies the information for the full schedule of intensification.
When taking the new drug with the famous chemical drug "rituximab", or as a single treatment, the most common adverse reactions included lack of immunity, thrombocytopenia, anemia, diarrhea, nausea, upper respiratory infection, cough, muscle and bone pain.
The manufacturer warns of the potential risk of tumor necrosis syndrome during the drug intensification stage and instructs doctors to advise patients on signs and symptoms.
– Health
Post a Comment